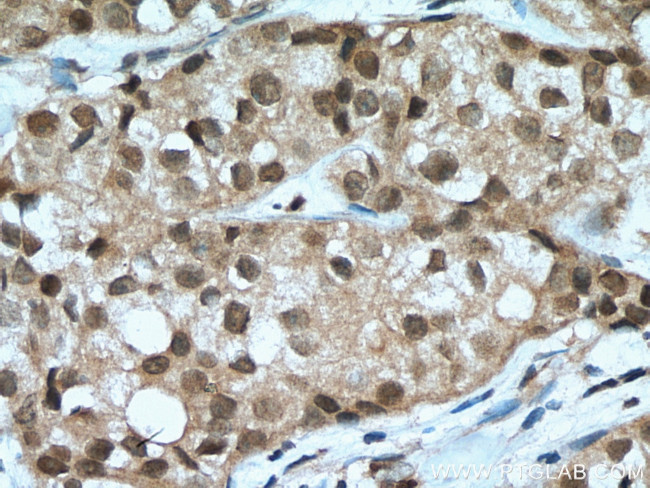
TOX2 Antibody in Immunohistochemistry (Paraffin) (IHC (P))

Search
Proteintech
TOX2 Polyclonal Antibody
{{$productOrderCtrl.translations['antibody.pdp.commerceCard.promotion.promotions']}}
{{$productOrderCtrl.translations['antibody.pdp.commerceCard.promotion.viewpromo']}}
{{$productOrderCtrl.translations['antibody.pdp.commerceCard.promotion.promocode']}}: {{promo.promoCode}} {{promo.promoTitle}} {{promo.promoDescription}}. {{$productOrderCtrl.translations['antibody.pdp.commerceCard.promotion.learnmore']}}
产品信息
21162-1-AP
种属反应
宿主/亚型
分类
类型
抗原
偶联物
形式
浓度
规格
纯化类型
保存液
内含物
保存条件
运输条件
产品详细信息
Immunogen sequence: SSPDQGETK STQANPPAKM LPPKQPMYAM PGLASFLTPS DLQAFRSGAS PASLARTLGS KSLLPGLSAS PPPPPSFPLS PTLHQQLSLP PHAQGALLSP PVSMSPAPQP PVLPTPMALQ VQLAMSPSPP GPQDFPHISE FPSSSGSCSP GPSNPTSSGD WDSSYPSGEC GISTCSLLPR DKSLYLT (303-488 aa encoded by BC007636 )
靶标信息
TOX2 (TOX High Mobility Group Box Family Member 2) is a Protein Coding gene. Diseases associated with TOX2 include Conduct Disorder. Gene Ontology (GO) annotations related to this gene include chromatin binding and RNA polymerase II transcription factor binding. An important paralog of this gene is TOX.
仅用于科研。不用于诊断过程。未经明确授权不得转售。
生物信息学
蛋白别名: GCX-1; granulosa cell HMG box 1; Granulosa cell HMG box protein 1; granulosa cell HMG-box protein 1; TOX high mobility group box family member 2; unnamed protein product
基因别名: AI851523; AV026525; BI987407; C20orf100; dJ1108D11.2; dJ495O3.1; GCX-1; GCX1; RxHMG1; TOX2
UniProt ID: (Human) Q96NM4
Entrez Gene ID: (Human) 84969, (Mouse) 269389